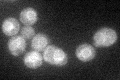
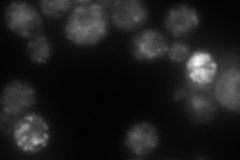
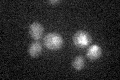

View description
UDP-glucose:dolichyl-phosphate glucosyltransferase, involved in asparagine-linked glycosylation in the endoplasmic reticulum
Localization:
Intensity:
Fold change:
Significance:
-
C’ GFP library in SD
ER32.62 -
N' NOP1pr-GFP in SD

punctate91.5692 -
N' TEF2pr-mCherry in SD
punctate83.3524 -
N' NATIVEpr-GFP in SD

punctate39.4891 -
N' TEF2pr-VC and Cyto-VN in SD

below threshold22.7696 -
C’ GFP library in SD+DTT

ER29.960.91No -
C’ GFP library in SD+H2O2

ER34.61.06No -
C’ GFP library in Starvation Media
ER23.750.72No -
C’ GFP library on the background of Pup2-DaMP

ER -
C’ GFP library on the background of CCT mutant

ER34.4371.05514No
